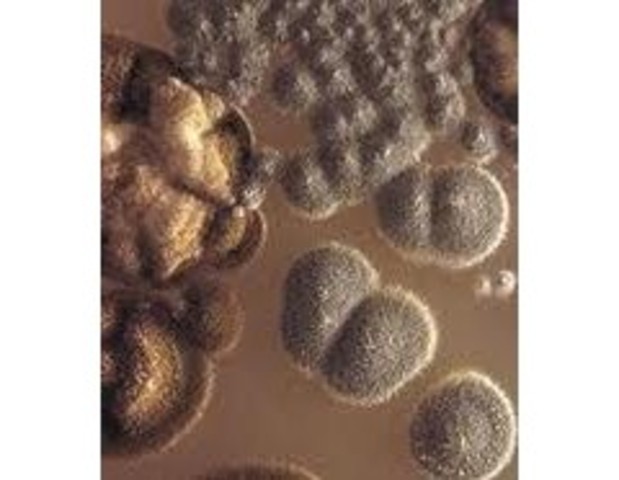
Francostoro
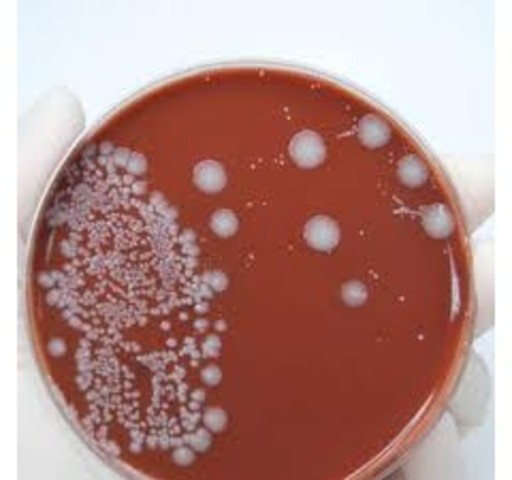
Robert Koch

-
Desarrollo del primer microscopio compuesto.
-
Lucrecio en su "De rerum natura" hace varias alusiones a "Semillas de enfermedad"
-
Las enfermedades pueden deberse a organismos pequeños
-
En el Renacimiento europeo se habla de gérmenes vivos.Girolamo Frascatorius en su libro "De contagione et contagionis" dice que las enfermedades contagiosas se deben a "gérmenes vivos" que pasan de diversas maneras de un individuo a otro.
-
Se empieza el trabajo con lentes.
La primera referencia sobre el microscópio se debe a Constantjin Huygens, quien relata que el inglés Cornelis Drebbel tenía en su taller un instrumento magnificador, que recibió el nombre de "Microscopium" en 1925, en la Accademia Dei Lincei, Roma. -
Se descubre a los hongos filamentosos y la estructura de las plantas.
Al mismo tiempo que Leeuwenhoek, el inglés Robert Hooke, usando microscopios compuestos, describió los hongos filamentosos y descubrió la estructura celular de las plantas acuñando el término célula. -
Se realizan experimentos para desacreditar la Generación Espontánea.
Esta doctrina de la “generatio spontanea” o abiogénesis, fue puesta en entredicho por los experimentos de Francesco Redi (1621-1697), quien había acuñado la expresión “Omne vivum ex ovo” (1668), tras comprobar que los insectos y nematodos procedían de huevos puestos por animales adultos de su misma especie. -
Antonie van Leeuwenhoek (tendero de Delf, HOLANADA) descubre pequeñas criaturas en una gota de agua.
-
Se llega a observar por primera vez a microorganismos invisibles al ojo humano
Este descubrimento fue obra de un comerciante holandés de tejidos, Antonie van Leeuwenhoek. Descubrió que en una gota de agua de estanque pululaba una asombrosa variedad de criaturas a las que denominó "animáculos". En 1683 descubre bacterias, por lo que se le considera el Padre de la Microbiología. -
(10000-7000 A.C) Fueron lossumerios, babilonios y, más exquisitamente, los egipcios los que emplearondirectamente a los microorganismos al desarrollar la fabricación del pan y lacerveza.
-
Anton van Leeuwenhoek, usando un microscopio de una sola lente que él mismo había construido basado en el modelo creado por el erudito Robert Hooke en su libro Micrographia, realizó la primera observación microbiológica registrada de "animáculos", como van Leeuwenhoek los llamó y dibujó entonces.
-
Describe las primeras observaciones realizadas con microscopios caseros de los microorganismos (llamados entonces animáculos) presentes en agua de lluvia, fuentes, mar y nieve así como de muestras tomadas de materia interdental
-
Robert Hooke desarrolla el microscopio compuesto
-
Los animaculos están en el aire
-
Eugenio Espejo (1747-1795) publicó importantes trabajos de medicina, como las Reflexiones acerca de la viruela (1785), el cual se convertiría en el primer texto científico que refería la existencia de microorganismos (inclusive antes que Louis Pasteur) y que definiría como política de salud conceptos básicos de la actualidad como la asepsia y antisepsia de lugares y personas.
-
Desarrolló la primera vacuna contra la viruela humana.
-
Establece tecnicas de aislamiento de microorganismos y medios de cultivo
-
Se considera fundada por el botánico Ferdinand Cohn (1828-1898). Cohn fue también el primero en formular un esquema para la clasificación taxonómica de las bacterias.
-
Descubre la mortalidad en parturientas por pasaje de materia putrefacta de las manos de los médicos.
-
Descubrió un hongo (Phytophthora infestans) que produce la podredumbre de la patata
-
Propuso la utilización de antisépticos para evitar la fiebre puerperal
-
Fue, efectivamente Louis Pasteur (1822-1895) el que asestó el golpe definitivo y zanjó la cuestión a favor de la teoría biogénica.
En un informe a la Académie des Sciences de París, en 1860 (“Expériences rélatives aux générations dites spontanées”) y en escritos posteriores comunica sus sencillos y elegantes experimentos: calentó infusiones en matraces de vidrio a los que estiraba lateralmente el cuello, haciéndolo largo, estrecho y sinuoso, y dejándolo sin cerrar, de modo que el contenido estu -
Refutó de manera convincente la teoría de la generación espontánea
-
Luis Pasteur con la Teoría biogénica destierra la teoría de la generación espontanea
-
Descubrió los ácidos nucleicos (DNA) en el esperma de trucha
-
Demostró que el carbunco o antráx era causado por Bacillus anthracis y en 1882 descubrió Mycobacterium tuberculosis
-
Descubrimiento de las endoesporas por ferdinad Cohn
-
Roberto Koch Descripción de técnicas de cultivo puro en medio sólido
-
Descubrimiento de las la etiologia de la tuberculosis por Rober koch.
-
Introdujo el uso de las placas Petri en Microbiología
-
Comprobó que el tratamiento térmico repetido permitía evitar el crecimiento de microorganismos en infusiones. Supone un primer desarrollo de métodos de esterilización de líquidos
-
llevó a cabo el descubrimiento de la transformación bacteriana.
-
Desarrolló el microscopio de contraste de fases que permite ver microorganismos vivos
-
inventó el microscopio electrónico
-
Aíslan la Penicilina
-
Descubren la enzima de transcriptasa reversa de RNA en los virus.
-
Puso a punto un test bacteriano para detectar mutágenos y carcinógenos: Test de Ames.
-
Confirmó que la fiebre amarilla era transmitida por mosquitos
-
Secuenciación del genoma de Saccharopolyspora erythraea, el microorganismo productor del antibiótico eritromicina.
-
Aparición en México de un brote de gripe porcina, posteriormente llamada gripe A H1N1.
Looking for a timeline maker?
Create timelines for projects, roadmaps, history, lessons, legal cases, and stories with Timetoast. Timetoast is a timeline maker for work, school, research, and stories.